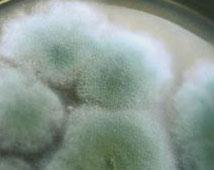
食用菌木霉

木霉孢子

木霉菌
图片尺寸1200x800
木霉菌 (农学)
图片尺寸3115x3115
木霉分类与鉴定(杨合同著3)
图片尺寸764x1016
深度好文建议收藏生防木霉菌的前世今生
图片尺寸451x504
一株拟康宁木霉菌及其在防治荔枝炭疽病中的应用的制作方法
图片尺寸1000x998
木质纤维素降解菌(左:里氏木霉;右:粗糙脉孢菌)(图片来源:作者整理)
图片尺寸878x338
长枝木霉
图片尺寸1440x1080
木霉
图片尺寸558x419
海洋生境棘孢木霉tcs007菌株的鉴定及抑菌活性
图片尺寸3150x1386
广西百泰微生物木霉菌简介
图片尺寸1280x960
一株多功能里氏木霉及其应用的制作方法
图片尺寸917x916
一种棘孢木霉及其应用制造技术
图片尺寸1000x764
如何控制霉菌污染食品?金华勇洁净车间臭氧杀菌处理!
图片尺寸600x418
中国木霉属七个土生新种,防霉剂研究需要新升级
图片尺寸640x846
哈茨木霉
图片尺寸800x457
木霉孢子萌发 拍摄:金漫▲木霉的产孢结构-瓶梗 图源:wikipedia到到
图片尺寸451x321
一株黄绿木霉t62321010菌株及其培养方法与应用与流程
图片尺寸878x1000
食用菌木霉
图片尺寸214x170
two chinese new records of the genus
图片尺寸694x779
中国木霉属七个土生新种防霉剂研究需要新升级
图片尺寸640x781